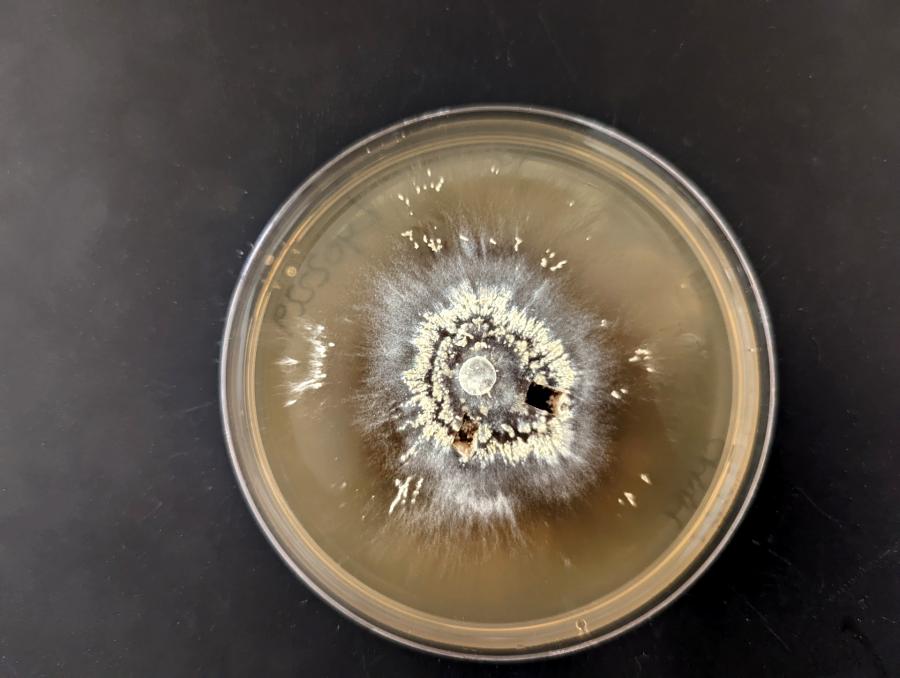

Мегапожарите са изключително опустошителни, но тези микроби процъфтяват в тях
Мегапожарите са изключително опустошителни, но тези микроби процъфтяват в тяхЗнаем, че съществуват организми, които са изключително издръжливи, които могат да оцелеят в космоса или в най-дълбоките недра на планетата. Група микроби обаче, идентифицирани в ново изследване, определено изпъкват над всички останали.
Изследването описва гъби и бактерии, които не само, че преживяват мегапожара от 2016 г. в Собъринс крийк, Калифорния, но и процъфтяват в резултат на него. Ако успеем да отговорим на въпроса „Как точно се случва това?“, бихме могли да подпомогнем усилията за възстановяването на регионите, засегнати от опустошителните пожари.
Допълнителен анализ разкрива, че микробите, които буквално се вкопчват в живота и впоследствие дори процъфтяват, са генетично свързани. Подобни откритие би могло да хвърли повече светлина върху начина, по който тези форми на живот успяват да преживеят пожарите.

Микробите, извлечени от обгорената от пожара почва. Източник: Jenna Maddox/UCR
„Те споделят адаптивни характеристики, които им позволяват да откликнат на огъня, и това подобрява нашата способност да предсказваме кои микроби ще реагират – било то положително или отрицателно – на събития от този тип“, казва микологът Сидни Гласман от Калифорнийския университет в Ривърсайд.
Първите почвените проби са взети през 2013 г. от участък, в който учените изследват внезапната смърт на дъбови дървета. Впоследствие те са съпоставени с проби, взети непосредствено след пожара през 2016 г. Не всички участъци са засегнати от пожара. Ето защо екипът дори разполага с „контролно“ място за сравнение.
Като цяло специалистите установяват до 70 процента спад в разнообразието на видовеге гъби, докато бактериалните видове падат с до 52 процента на проба. Някои бактериални групи обаче, включително актинобактериите (които подпомагат разграждането на растителния материал) и фирмикутите (които подпомагат растежа на растенията и регулират патогените), процъфтяват.
Що се отнася до гъбите, специалистите установяват, че чувствителната на топлина Basidioascus се е увеличила значително. Тя разгражда различни компоненти на дървото, включително лингин (здравата част от растителните клетъчни стени, която поддържа формата им и ги предпазва).
Penicillium също се справя доста добре в огъня и сега екипът си е поставил за цел да установи как тези разнообразни микроби са увеличили броя си. Най-вероятно различните видове са използвали различни методи.
„Penicillium вероятно се е възползвал от храната, отделена от некромасата (или „мъртвите тела“) и някои видове вероятно могат да ядат дори въглен“, казва Гласман.
Мегапожарите са изключително интензивни горски пожари, които унищожават големи територии. Характеризират се по своите размери, продължителност, интензитет и неконтролируемост.
Понятието мегапожар е възможно да варира между различните региони и държави. В Европа мегапожарите са пожари, засягащи най-малко 1000 хектара (2470 акра), докато в САЩ и на други места като такива могат да се квалифицират пожари, които започват от 10 000 хектара (24 710 акра)
Изследване на NASA от 2019 година разширява дефиницията за мегапожар, като интегрира множество фактори: „С глобалното затопляне и почти цял век на политика по недопускане на пожари, горските пожари днес са станали много по-екстремни като размери, катастрофичност, сложност на поведението и устойчивост на потушаване. Такива пожари е станало обичайно да се наричат мегапожари и в историческите си вариации достигат до крайности.“
Съгласно едно наблюдение, направено през 2019 година, само 3% от всички пожари на планетата достигат до статут на мегапожари, но при все това причиняват повече от 50% от унищожените земни площи.
През последните години, няколко пожара достигат над един милион акра, превръщайки се по същество в т.нар. гигапожари. В това число влизат Пожарът в националния парк Йелоустоун от 1988 година в Монтана и Айдахо, при който изгарят 1,58 милиона акра; пожарът в комплекса Тейлър в Аляска, при която изгарят 1,3 милиона акра през 2004 година, пожарите, унищожили 1,5 милиона акра в австралийските щати Виктория (щат) и Ню Саут Уелс през 2020 година и пожарите в Калифорния през 2020 година.
Следващата цел на изследователите е да открият как тези стратегии за оцеляване на гъбите и микробите могат да бъдат приложени към усилията за възстановяване на горите.
„Малко вероятно е растенията да могат да се възстановят от тези мегапожари без благотворното влияние на гъбите, които снабдяват корените с питателни вещества, или на бактериите, които трансформират допълнителния въглерод и азот в обгорената от пожара почва – казва Гласман – За да могат нашите възстановителни усилия да бъдат успешни, трябва да научим повече за тези микроби.“
Изследването е публикувано в Molecular Ecology.
Източник: Science Alert